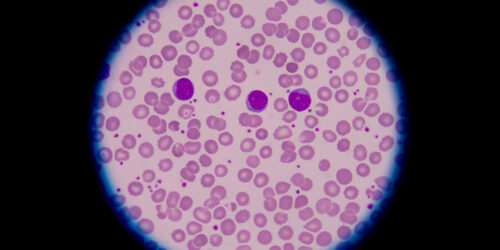
Everything you need to know about blood disorders

Ways to plan and lead a cholesterol-friendly life
Cholesterol is a fatty wax substance that the body naturally produces to support certain digestive functions. However, high levels of cholesterol can increase the risk of stroke, high blood pressure, and heart problems. There are two main types of it: High Density Lipoprotein (HDL) and Low Density Lipoprotein (LDL). Medical professionals refer to HDL as good cholesterol that comes from healthy, organic, and natural food sources while LDL is a bad byproduct of processed foods rich in additives.
Read More